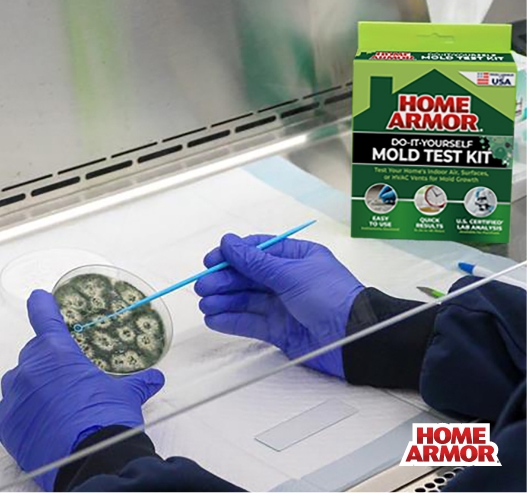

Home Armor Mold Test Kit Lab Analysis
Gain deeper insight into your DIY Mold Test Kit* sample with a full lab report identifying the mold types present and offering remediation guidance from our ISO 17025 accredited U.S. lab.
*Test Kit sold separately. You must have a test kit to purchase a lab analysis.
$50
How It Works
- Purchase a Home Armor mold test kit at a retailer near you and use it to collect your sample using one of the supported testing methods (indoor air, surface, or HVAC).
- Purchase the Lab Analysis here. Complete the analysis purchase form with your test kit ID, sample details, and testing location.
- Pack your sample in the prepaid shipping envelope included in your store-bought test kit purchase.
- Mail your sample to our U.S.-accredited laboratory using the prepaid envelope provided.
- Receive your comprehensive lab report to your email, including mold identification results and clear guidance for next steps and remediation.
Why It’s Worth It
Trusted Results – Get scientifically reliable results from our accredited lab, where trained microbiologists analyze your sample with accuracy and precision.
Peace of Mind – Know exactly what type of mold is present in your home and receive remediation guidance, so you can move forward confidently.
Easy & Convenient – Just place the prepaid envelope with your mold sample in the mailbox. You will receive your comprehensive lab report by email.
Take action with confidence.
Learning you have mold often leads to more questions and concerns. Our US accredited lab uses trained microbiologist to deliver accurate and precise results you can trust.





